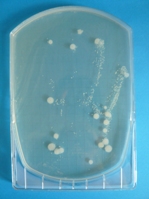

椎葉中 今日の給食
06/16: 手洗いはしっかりと!
先におことわりしますが・・・
食事中の方、この記事は後でご覧ください。
(下のほうに、食欲を低下させる写真が出てまいります・・・^^;)
梅雨に入りました。
これからジメジメした季節。
食品もいたみやすくなる時期ですね。
冷蔵庫を過信せずに、食中毒に気をつけましょう!
さて、本題に入ります。
日頃から、生徒には「せっけんを使った手洗い」を呼びかけ、「アルコール噴霧」を行っています。
うんうん、頭では分かっているのでしょうが、なかなか行動に移せない・・・
給食当番に急いでいるときなど、ついつい簡単な手洗いになりがちです。
そこで、宮崎県学校給食会にお願いして、「フードスタンプ」という、手の細菌を調べるキットをお借りしました。
【実験結果の見方】
保体委員の生徒3名に協力してもらい、実験を行いました。

↑ 寒天培地にペタンとしてもらい、その後37℃で菌を培養しました。
? 壁や手すり、髪の毛などをわざと触った手
(泥などを触ったわけでなく、通常の生活で触るところの菌を調べるためです。)
? ?のところを触ったそのままの手に、アルコールを噴霧した手
? 水洗いのみ
? せっけん洗い
? せっけん洗い後にアルコール
この5つについて、比較実験を行いました。
↓
↓
↓
壁や手すり、髪の毛などをわざと触った手
壁や手すり、髪の毛などを触ったそのままの手に、
アルコールを噴霧した手
菌が激減したのは、アルコールに加え、実験のためにペーパータオルで
手をふき取ったことが考えられます。
水洗いのみ
せっけん洗い
せっけん洗い後にアルコール

結果はご覧の通りです。
水洗いだけですと、逆に指紋の中の汚れが浮き出てくるようですね。

生徒には、展示をして知らせました。
「うわぁ〜、きたない!」と、とてもよい反応でした(^-^)
さすがに触る生徒もいなかったようです。
食事中の方、この記事は後でご覧ください。
(下のほうに、食欲を低下させる写真が出てまいります・・・^^;)
梅雨に入りました。
これからジメジメした季節。
食品もいたみやすくなる時期ですね。
冷蔵庫を過信せずに、食中毒に気をつけましょう!
さて、本題に入ります。
日頃から、生徒には「せっけんを使った手洗い」を呼びかけ、「アルコール噴霧」を行っています。
うんうん、頭では分かっているのでしょうが、なかなか行動に移せない・・・
給食当番に急いでいるときなど、ついつい簡単な手洗いになりがちです。
そこで、宮崎県学校給食会にお願いして、「フードスタンプ」という、手の細菌を調べるキットをお借りしました。
【実験結果の見方】
保体委員の生徒3名に協力してもらい、実験を行いました。
↑ 寒天培地にペタンとしてもらい、その後37℃で菌を培養しました。
? 壁や手すり、髪の毛などをわざと触った手
(泥などを触ったわけでなく、通常の生活で触るところの菌を調べるためです。)
? ?のところを触ったそのままの手に、アルコールを噴霧した手
? 水洗いのみ
? せっけん洗い
? せっけん洗い後にアルコール
この5つについて、比較実験を行いました。
↓
↓
↓
壁や手すり、髪の毛などをわざと触った手
壁や手すり、髪の毛などを触ったそのままの手に、
アルコールを噴霧した手
菌が激減したのは、アルコールに加え、実験のためにペーパータオルで
手をふき取ったことが考えられます。
水洗いのみ
せっけん洗い
せっけん洗い後にアルコール
結果はご覧の通りです。
水洗いだけですと、逆に指紋の中の汚れが浮き出てくるようですね。
生徒には、展示をして知らせました。
「うわぁ〜、きたない!」と、とてもよい反応でした(^-^)
さすがに触る生徒もいなかったようです。